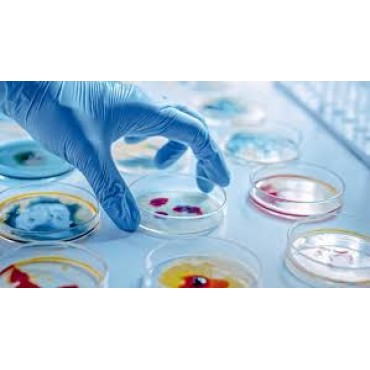

pH-indicator strips pH 0 - 14 Universal indicator
pH-indicator strips pH 0 - 14 Universal indicator..
Analitik Terazi
AS.X2 serisi, hassas teraziler için yeni gelişmiş bir seviyeyi temsil etmektedir.X2 serisi teraziler..
Anemometre (Hava Hızı) (Cep Tipi)
Testo 410-1Zamana bağlı değer hesabıHold fonksiyonu ve maks./min. değerlerAçık hava için rüzgar soğu..
Anemometre (Hava Hızı, Sıcaklık, Nem) (Cep Tipi)
Testo 410-2Zamana bağlı ortalama değer hesabıHold fonksiyonu ve maks./min değerlerAçık hava için rüz..
App Bağlantılı Termohigrometre
Testo 625 Hava sıcaklığı ve bağıl nemin basit, hızlı ve hassas ölçümüÇiğlenme noktası ve yaş kü..
Baca Gazı Analiz Cihazı
Testo 300 İleri Seviye Uzun Ömürlü Set 4Set içeriği: testo 300 İLERİ SEVİYE uzun ömürlü baca gazı an..
Bluetootlu Pervane Seti
Testo 440 Bluetootlu 100 mm Pervane Setiİklimle ilgili tüm parametreler için tek ölçüm cihazıAkıllı:..
Çalkalamalı Su Banyosu
ST 30Tank kapasitesi: 30 litreSıcaklık çalışma aralığı: Ortam sıcaklığı +5°C ile 99,9°C20-250 rpm ar..
Daldırma Problu Sıcaklık Ölçer
Testo 925Termokupl K Tipi prob ile kolay, hızlı ve hassas sıcaklık ölçümü (1 TC K Tipi prob dahildir..
Dijital Multimetre
Testo 760-3Otomatik ölçüm parametresi tanıma sayesinde kolay ve güvenilir çalışmaÇevirmeli düğme olm..
Etüv (Kuru Hava Sterilizatörü)
FN 400 / 500İki farklı hacim: 48 ve 120 litreÇalışma sıcaklığı sınırları: Ortam sıcaklığı +5°C ile 2..
Etüv (Kuru Hava Sterilizatörü)
FN 055/120 İki farklı hacim: 55 ve 120 litreÇalışma sıcaklığı sınırları: Ortam sıcaklığı +5°C i..
Fark Basınç Ölçüm Cihazı
Testo 510Çanta formatında sıcaklık ve hava sızdırmazlığı kompanzasyonlu fark basınç ölçümüAydınlatıl..
Hava Hızı ve İç Hava Kalitesi Ölçüm Cihazı
Testo 440 İklimle ilgili tüm parametreler için tek ölçüm cihazıBüyük prob portföyü ile genişlet..